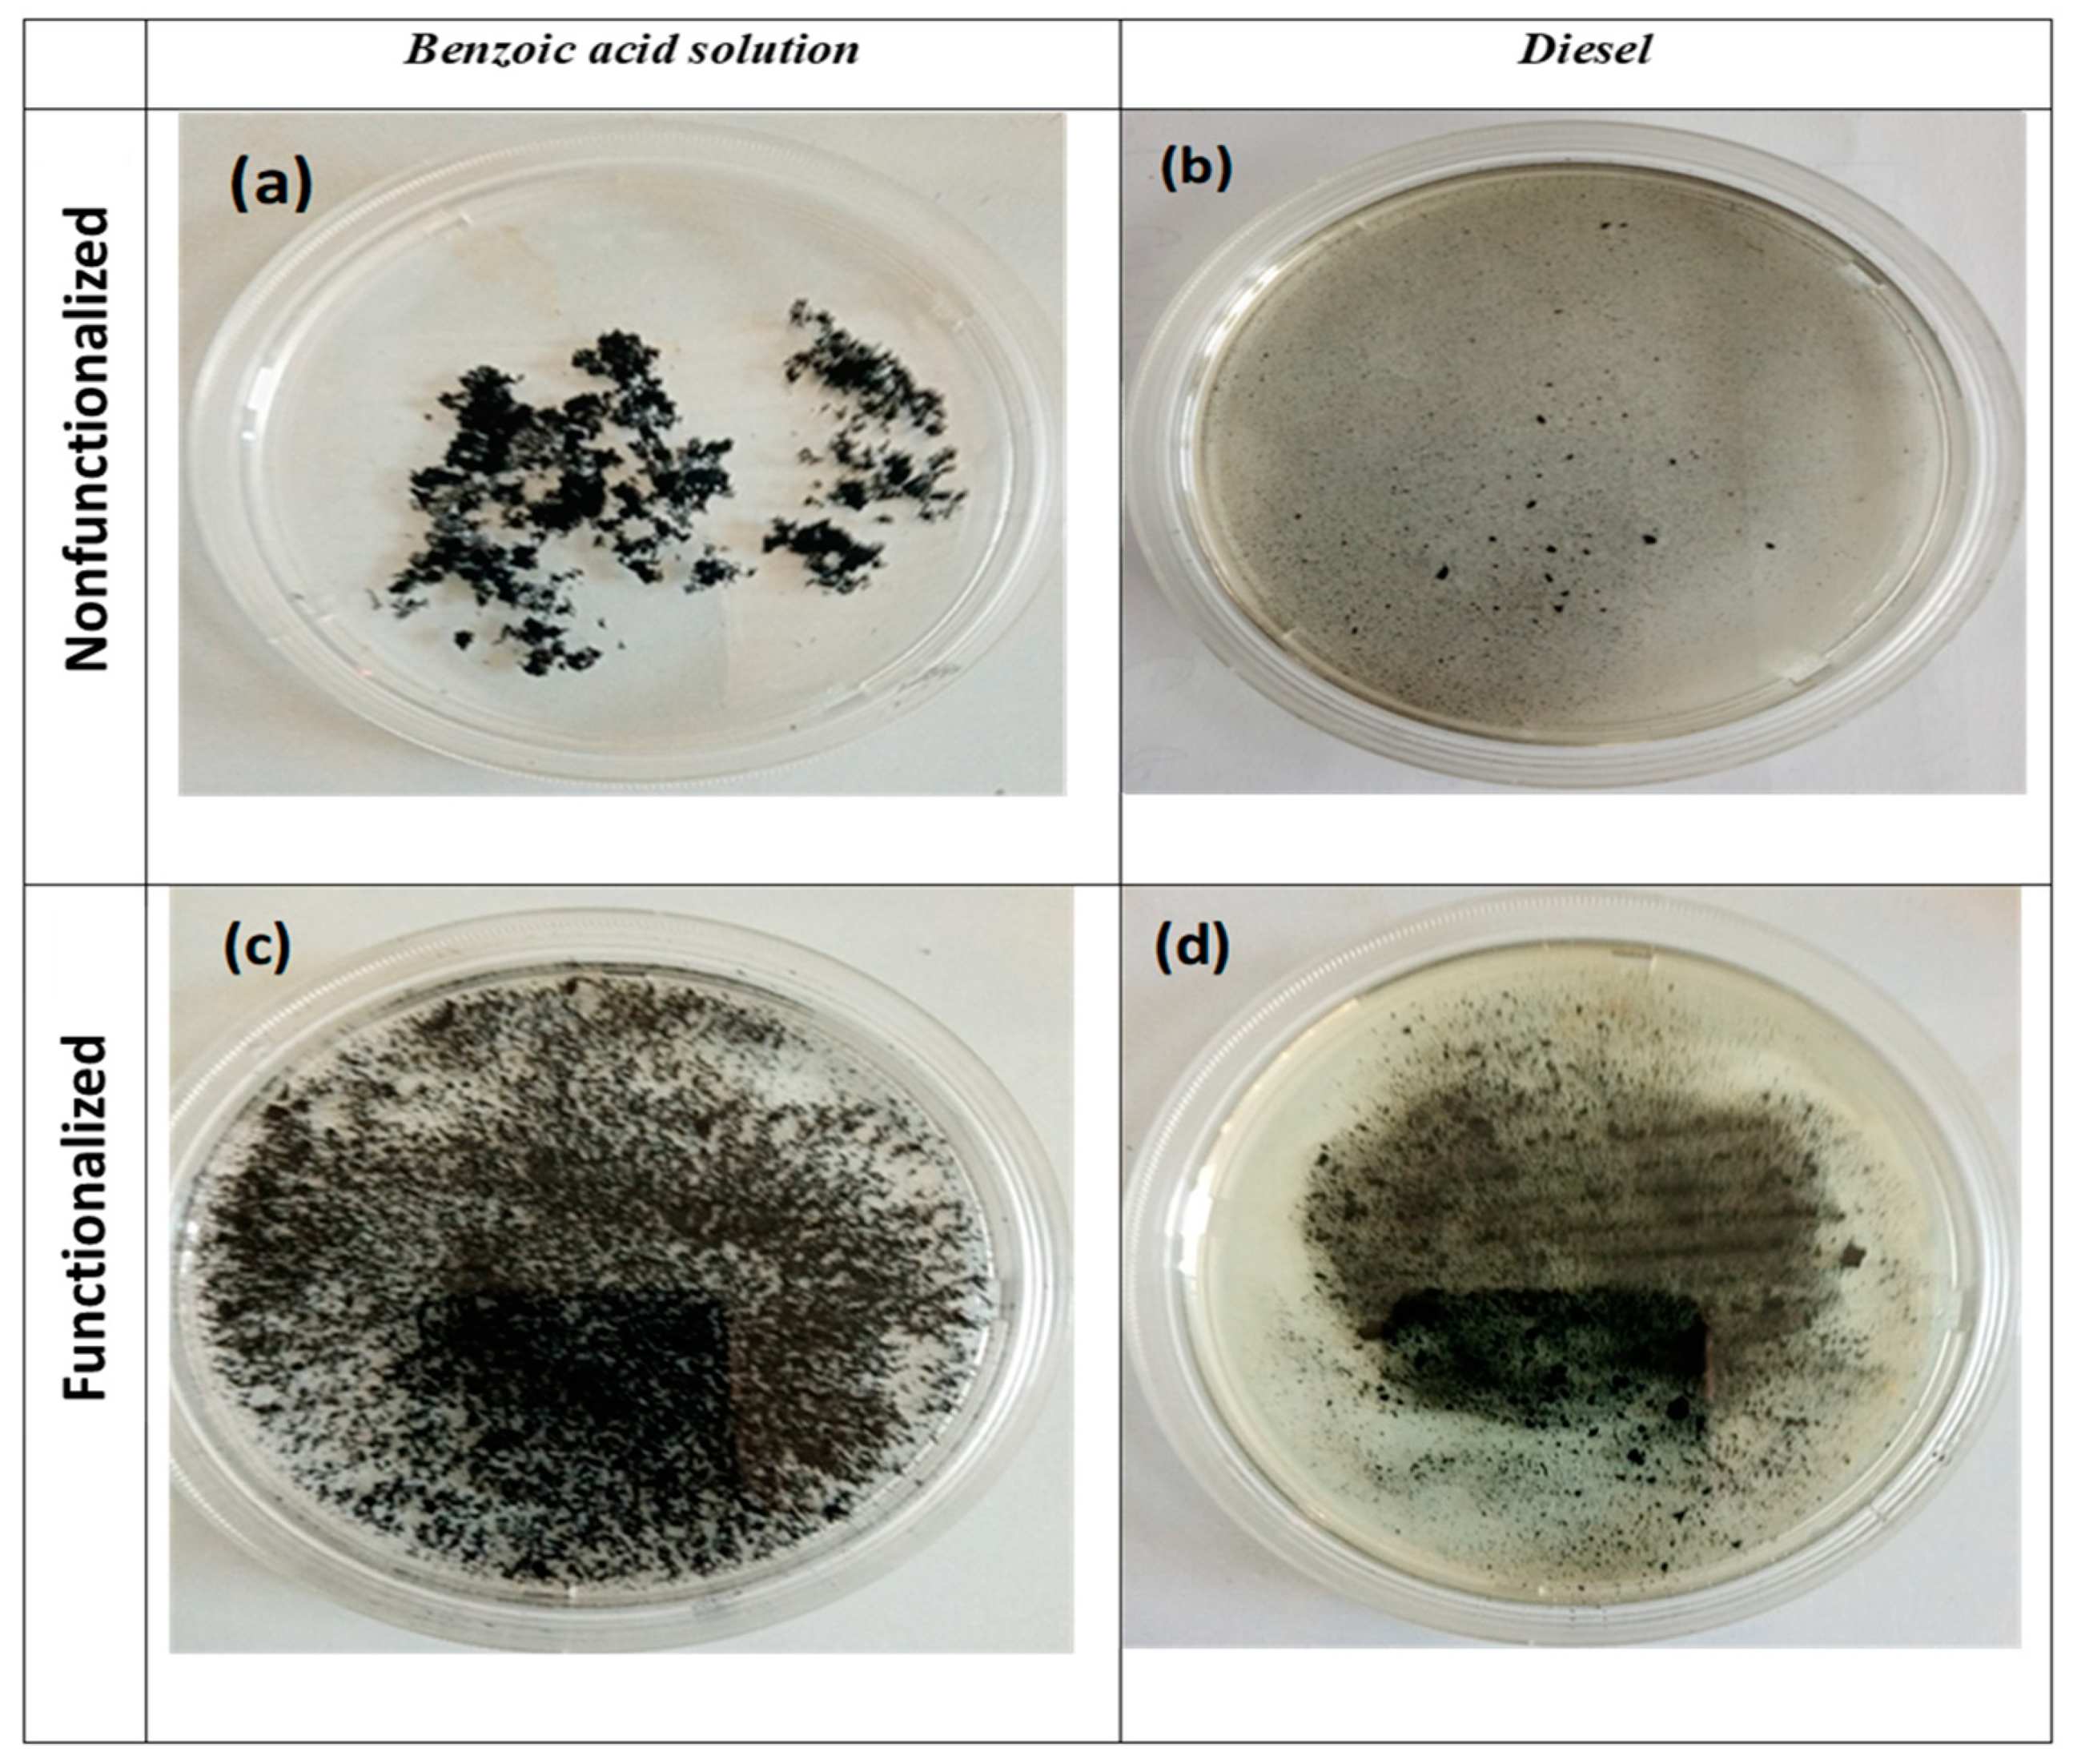
Inorganics 12 00238 g013

1. Introduction
Since 1991, the year in which they were discovered by the researcher Iijima, carbon nanotubes have attracted much attention and interest thanks to their peculiar properties [
1]. Carbon nanotubes can be considered rolled graphene sheets capable of forming tubes with diameters of nanometric dimensions and lengths that can vary from a few nanometers to a few centimeters. There are two fundamental types of nanotubes: single-wall carbon nanotubes (SWCNTs), made of a single graphite sheet, and multiwall carbon nanotubes (MWCNTs), made of multiple concentric graphene sheets [
2]. Carbon nanotubes are considered among the more resistant and harder materials; these characteristics derive from the type of bonds that are present in their structure, in which the carbon is sp
2 hybridized [
3]. Thanks to these peculiar properties, carbon nanotubes have been studied in various fields of application, such as electronics [
4], medicine [
5,
6,
7], and biology [
8,
9]. Thanks to their mechanical properties, carbon nanotubes can be used as reinforcers in composite nanomaterials [
10,
11,
12]. A particular field of application in which nanotubes have shown great potential is water purification. The demand for waste and industrial water treatment is increasingly looming and consequently growing, especially in emerging countries as industrialization processes increase. Water pollutants are of many types and vary in origin and chemical nature [
13,
14]. Among the types of contaminated water, there are those of civil origin, which derive from city wastewater that flows into rivers or directly into the sea without any purification treatment; those of industrial origin, which are made up of different substances depending on the industrial production; and agricultural ones, which are related to the excessive and incorrect use of fertilizers and pesticides, which, being generally water-soluble, penetrate soil and contaminate aquifers.
Industrial waste contains a large quantity of pollutants, and their composition varies depending on the type of production process. Their impact on the environment is complex; often the toxic substances contained in these discharges mutually reinforce their harmful effects and, therefore, the overall damage is greater than the sum of the individual effects. The chemical fertilizers used in agriculture and the sewage produced by livestock are rich in organic substances which, when washed away by rain, end up flowing into aquifers or surface water bodies [
15,
16,
17]. Carbon nanotubes have been advantageously studied for the purification of water contaminated by hydrocarbons [
18,
19,
20] and dyes [
21,
22,
23,
24].
Given the great variety and characteristics of possible water contaminants, in each specific case of water treatment, a careful choice of the adsorbent to use is essential. To be effective, the adsorbent must have a certain affinity toward the contaminant to be removed. Carbon nanotubes, due to their structure, have a highly hydrophobic character.
The removal of pollutants present in water through the adsorption technique has been conducted for years. Among the most commonly and traditionally used adsorbent materials are activated carbons and polymers. These are easily available and cheap materials, but they are not always sufficiently effective in the removal of particular pollutants. Their limitations are due to their low capacity and selectivity of adsorption, as well as the difficulty in modifying their surfaces for specific uses. Carbon nanotubes, on the other hand, have high adsorption capacities that are superior to other adsorbent materials used under similar conditions. In addition to their large surface area, carbon nanotubes are distinguished from traditional ones by the possibility of functionalizing their surfaces, giving them a particular specificity and selectivity for the removal of pollutants.
The so-called “functionalization” allows for the surfaces of carbon nanotubes to be modified, which can lead to incisive modification of the hydrophobic character [
25]. There are mainly two different functionalization methods: “covalent” and “non-covalent”. With the covalent functionalization method, functional groups, commonly hydroxyl and carboxyl, are created on the surfaces of carbon nanotubes. The structures of the carbon nanotubes near the attachment of functional groups change the hybridization from sp
2 to sp
3. Covalent functionalization can be carried out with strongly oxidizing acid mixtures consisting of sulfuric acid and nitric acid [
26,
27]. Other methods involve fluorination reactions that initially lead to the formation of -C-F bonds on the surfaces of the nanotubes. Since these bonds are weak, they subsequently allow for the replacement of the fluorine with other groups, for example, amine or hydroxyl [
28,
29].
In “non-covalent functionalization”, unlike the previous method, there is no modification of the structure, but it becomes more accessible and active for the establishment of weak secondary bonds with adsorbed molecules. The method mainly involves the following three steps: sonication of the nanotubes in water, centrifugation, and filtration. Using this method, many molecules, such as biomolecules, surfactant polymers, and aromatic organic molecules, can interact with the surfaces of carbon nanotubes through the establishment of weak molecular interactions [
30]. In this research, particular attention was paid to the role played by functionalization in the removal of two common and chemically different pollutants in water. Benzoic acid is a versatile compound that finds applications in various industrial sectors. It is used as a preservative in food products and is identified as E210 in food products [
31]. In the pharmaceutical industry, it is used as an ingredient in topical preparations. However, approximately 90% of the benzoic acid on the market is used to produce plastic as an intermediate for the production of plasticizers, resins, and other compounds. Benzoic acid is also used as an activator and retarder in the polymerization of rubber. Benzoic acid is toxic in excessive doses, and its accumulation in the environment can have adverse effects [
32,
33]. Its release in large quantities can alter local ecosystems. Its presence in industrial wastewater is a cause for concern and requires adequate treatment methods to minimize the environmental impact. Accidental spills of oil or its derivatives, as well as diesel, are a threat to marine and terrestrial ecosystems, with devastating consequences for the environment and biodiversity. They cause irreversible damage to the surrounding fauna and flora. Furthermore, this type of pollution can persist for years, negatively affecting air and soil quality. Coastal communities and marine organisms are particularly vulnerable, with long-term impacts on food security and human health. The management and prevention of pollution from organic fuels, as these are made up of a multitude of organic molecules, require the development and optimization of new technologies for their timely and effective recovery. In this article, two case studies that consider the treatment, with carbon nanotubes, of waters contaminated by two different common pollutants, diesel and benzoic acid, are compared in depth, continuing the research reported in our previous articles [
34,
35]. These two pollutants were taken as references because they represent two fundamentally different types of molecules. In fact, diesel is substantially made up of nonpolar molecules and, therefore, representative of nonpolar pollutants, while benzoic acid can be considered representative of pollutants characterized by polar molecules. To highlight the factors that allow for the effective optimization of the water purification process, the influence of the functionalization of carbon nanotubes was studied based on the nature of the polluting molecules to be treated.
3. Results and Discussion
3.1. Characterization of Nanotubes before Adsorption Tests
The carbon nanotubes, before being used in the various adsorption tests, were characterized.
3.1.1. Microanalysis (EDS) and Electron Microscopy
Each sample was scanned at different points by EDS microanalysis to have the most complete possible overview of chemical characteristics of the samples. The observation highlighted the homogeneity of the samples. The representative EDS of the different samples are reported below.
Figure 4 reports the spectra of the EDS microanalysis carried out on the nonfunctionalized (
Figure 4a) and functionalized (
Figure 4b) carbon nanotubes. Although the EDS method does not allow for a precise determination, it was sufficient for the purpose of this research, since it allows us to highlight the main and substantial differences among the different samples.
The EDS microanalysis (
Figure 4a) determined for the nonfunctionalized carbon nanotubes a composition of 98.2% carbon, low percentages of oxygen of around 1.5%, attributable to possible defects, and insignificant percentages of chlorine of 0.3%, attributable to impurities. The high percentage of carbon confirms the high quality of the nonfunctionalized carbon nanotubes.
The EDS analyses (
Figure 4b) highlight a significant decrease in the percentage of the carbon content equal to 78.9% and an increase in the oxygen percentage equal to 15.1%. This shows that the functionalization treatment led to the creation of -COOH groups. Traces of sulfur were also visible, equal to 5.1%, justifiable as residues of the functionalization treatment with sulfuric acid and traces, although not very significant, of other elements to be considered as impurities.
SEM images of the nonfunctionalized (
Figure 5a) and functionalized (
Figure 5b) carbon nanotubes are shown below.
From observations of the samples, the nonfunctionalized carbon nanotubes (
Figure 5a) were well-formed with diameters ranging between 20 and 36 nanometers. They appeared poorly isolated and in bundles.
The functionalized carbon nanotubes (
Figure 5b) do not show significant morphological variations compared to the nonfunctionalized ones, but compared to the former they appear more isolated and less organized in bundles, modifications which are attributable to the functionalization process. The diameters remain more or less like the previous ones.
As is known, functionalization is an essentially superficial process; therefore, the nonvariation in the diameters can be easily justified, as a single nanotube does not change its diameter but only presents more functional groups on the surface.
In summary, it is possible to state that from the microstructural observations, before and after functionalization, there were no variations in the nanotubes individually but in in the interactions among the nanotubes instead. When they are nonfunctionalized, they appear nonisolated and as if organized in bundles, while after functionalization they appear more isolated. In fact, the functionalization process with the insertion of carboxylic groups on the surface makes them less available for their aggregation. Generally, the limitations of nonfunctionalized nanotubes are that they organize into bundles and often have difficulty dispersing in the different systems in which they are used. The presence of functional groups after the functionalization process causes the phenomena of repulsion among the functional groups and steric hindrance among the single nanotubes, which favor the dissolution of the bundles and their greater dispersion. These behaviors were observed for all samples of functionalized nanotubes.
3.1.2. Thermogravimetric Analyses
Figure 6 shows the results of the thermogravimetric analysis (TG) carried out on the carbon nanotube samples synthesized as reported in
Section 2.1. The TG curve shows a significant weight loss between 500 and 650 °C attributable to the combustion of carbon nanotubes, in complete agreement with what is reported in the literature. The thermal behavior of the functionalized nanotubes, verified during the experimentation, showed a similar trend, without variations.
Thermal analyses (TG) were carried out on the functionalized and nonfunctionalized carbon nanotube samples after the adsorption tests for both benzoic acid and diesel. The aim was to highlight the different behaviors of the two types of carbon nanotubes depending on the different natures of the adsorbed pollution.
Figure 7 shows the TG curves of the functionalized and nonfunctionalized carbon nanotubes after the adsorption tests with benzoic acid.
From a comparison of the two thermal curves (TG), different thermal profiles for the two types of carbon nanotubes can be seen. This confirms, as already highlighted previously, that functionalized carbon nanotubes have a better propensity to adsorb benzoic acid than nonfunctionalized carbon nanotubes. In both cases, there is a weight loss of around 600 °C, which can logically be attributed to the combustion of carbon nanotubes. The differences are highlighted at temperatures below 600 °C; in fact, the weight losses attributable to benzoic acid were significantly greater in the case of the functionalized nanotubes compared to the nonfunctionalized ones. In particular, at up to 500 °C, there occurred weight losses of approximately 10% and 30%, respectively, for the functionalized and nonfunctionalized nanotubes
Figure 8 shows a profile of the nonfunctionalized carbon nanotubes after the adsorption tests with diesel. This profile is representative and alike to what was also found for functionalized carbon nanotubes.
At 600 °C, weight losses attributable to the combustion of carbon nanotubes occurred, and below this temperature significant weight loss validates the high adsorption of diesel. The data from thermogravimetric analyses confirm that depending on the nature of the pollutant, the carbon nanotubes performed well if they were nonfunctionalized or functionalized. In summary, it is possible to highlight that the thermal analysis (TG) profiles of nonfunctionalized and functionalized nanotubes, carried out after the adsorption tests on the same pollutant, demonstrate the fundamental role of functionalization in the optimal removal of pollutants. The need to functionalize must be taken into consideration in advance based on the pollutant to be removed. In fact, the thermal analysis profiles highlighted how nonfunctionalization is advantageous in the case of diesel adsorption, indicated by the greater weight loss, unlike the adsorption of benzoic acid, which instead showed a greater weight loss in the case of functionalized nanotubes.
3.2. Adsorption of Benzoic Acid by Functionalized and Nonfunctionalized Carbon Nanotubes
Below are reported the results of the adsorption tests using functionalized and nonfunctionalized nanotubes for water polluted by benzoic acid and diesel, respectively. For the understanding and discussion of the data obtained, particular attention was paid to the following:
- -
The different molecular structures of the two pollutants considered;
- -
The different dispersing capacities of the functionalized and nonfunctionalized nanotubes in the two systems considered.
Figure 9 shows the percentages of benzoic acid adsorbed as a function of the treatment times for the two systems containing nonfunctionalized and functionalized carbon nanotubes.
The reported data (
Figure 9) highlight that functionalized carbon nanotubes have a greater capacity to adsorb benzoic acid compared to nonfunctionalized ones.
This different capacity is more marked in the first minutes of adsorption and then decreases over a long period of time (
Table 1), attributable to the decrease in functional active sites.
3.3. Adsorption of Diesel by Functionalized and Nonfunctionalized Carbon Nanotubes
Figure 10 shows the % diesel adsorbed after the tests conducted at different times and using functionalized and nonfunctionalized carbon nanotubes.
The data reported above do not highlight particular differences in the diesel adsorption between nonfunctionalized and functionalized nanotubes.
3.4. Polarity and Solubility of Benzoic Acid and Diesel
An important parameter in determining a greater or lesser propensity toward adsorption with functionalized or nonfunctionalized carbon nanotubes is the polarity of the adsorbed molecule. If a molecule is made up solely of nonpolar covalent bonds, the molecule is nonpolar. If a molecule is made up of polar covalent bonds, the molecule is not necessarily polar, but it depends on its geometry. In fact, if the molecule has a structure such that the distribution of charges is symmetrical, the molecule appears nonpolar.
In the two cases taken as references in this study, benzoic acid is a molecule that structurally presents itself as a polar molecule due to the presence of the carboxyl functional group (
Figure 11).
Also contributing to the polarity of the entire structure is the resonance effect present on the benzoic acid molecule (
Figure 12).
Because of these peculiarities, benzoic acid is soluble in water, the latter being, as is known, a polar solvent. In particular, the solubilities of benzoic acid in water at 25 °C and 100 °C are 3.44 g/L and 56.31 g/L, respectively. This means that if the carbon nanotubes are in such conditions that their dispersion in water is favored, the adsorption of benzoic acid, present as a pollutant in water, is improved. Diesel, the other pollutant taken as a reference in this research, does not have a specific formula because it is not a single compound. It is made up of a mixture of saturated hydrocarbons and aromatic hydrocarbons containing mainly from 14 to 20 carbon atoms (
Table 2). It has a density between 0.84 and 0.88 g/cm
3. The organic molecules that constitute it are predominantly nonpolar, and therefore, it is insoluble in polar solvents such as water.
Therefore, if water is polluted by benzoic acid, not in a supersaturated condition, it is solubilized in solution, while in the case of diesel, it appears as a separate floating phase (Figure 14a). In the two cases above, the carbon nanotubes act in the following two different contexts: in a polar aqueous monophasic system when the water is contaminated by benzoic acid and in a biphasic system consisting of a polar and a nonpolar phase when the waters are contaminated by diesel. In these different contexts, the hydrophilic or hydrophobic character of the adsorbent material is then decisive.
3.5. Dispersive Capacity of Nonfunctionalized and Functionalized Nanotubes
A hydrophilic adsorbent material will perform better in a system in which the pollutant is solubilized in an aqueous phase, while in the case of a nonpolar pollutant, the optimal adsorbent is the hydrophobic one. The dispersing capacities in the different phases of the adsorbent material are crucial for optimal purification and therefore must be simultaneously evaluated with the other parameters. For the reasons stated above, the dispersing capabilities of carbon nanotubes, in polar or apolar phases, were studied in relation to their nonfunctionalization or functionalization.
This hydrophobic character makes the dispersion of carbon nanotubes in water difficult. Poor dispersion means that the nanotubes are not distributed uniformly in an aqueous system to be treated but often results in the formation of agglomerates. The latter reduce the accessibility of pollutants to the surface of the nanotubes with a consequent lowering of the adsorption capacity. Therefore, when the pollutant is present in aqueous systems, this aspect must be taken into careful consideration.
Figure 13 shows images of the dispersion of carbon nanotubes, functionalized and nonfunctionalized, for the pollutants treated in this research. In particular,
Figure 13a shows an image of the nonfunctionalized carbon nanotubes dispersed in water contaminated by benzoic acid. In this case, it is possible to observe that the hydrophobic character of the nonfunctionalized nanotubes did not allow for adequate and homogeneous dispersion within the system. The situation is completely different if functionalized nanotubes are used in the same system (
Figure 13c). In the latter case, the dispersion was homogeneous, and the nanotubes appeared to have agglomerated only a little. The comparison of the aforementioned situations makes it obvious and justifies the data obtained on adsorption; that is, nanotubes functionalized in water contaminated by benzoic acid are better performing.
Figure 13b,d show the images related to the diesel in which the nonfunctionalized and functionalized nanotubes were dispersed, respectively. From the images, it can be observed that the nonfunctionalized nanotubes dispersed excellently in the diesel, while the functionalized nanotubes showed a decrease in dispersing capacity.
However, in the case of biphasic systems characterized by a floating apolar phase, made up of the pollutant, on a polar aqueous phase, it is more particular, as follows: if a hydrophilic adsorbent is used, this will disperse in the aqueous phase and it is from here that it will act to adsorb the nonpolar molecules present in the swimming phase; if the adsorbent has a hydrophobic character, it will disperse mainly in the apolar phase, and it is here that it will act directly to adsorb the polluting molecules.
In the specific case of a water/diesel system (
Figure 14a), the nonfunctionalized nanotubes, having a hydrophobic character, are uniformly distributed in the diesel phase and absorb the organic molecules (
Figure 14b).
When the functionalized nanotubes were used (
Figure 14c), they lost their hydrophobic character and were distributed in the aqueous phase. If an adequate extension of the interface is guaranteed, they adsorb organic molecules without difficulty at the boundary between the diesel and water phases.
3.6. Characterization of Carbon Nanotubes after Adsorption Tests
The images in
Figure 15 show the carbon nanotubes recovered after the adsorption tests and dried in an oven at 100 °C for 48 h.
A substantial difference was evident between the nanotubes subjected to tests with benzoic acid and diesel. Regardless of the nature of the carbon nanotubes, functionalized or nonfunctionalized, those used with benzoic acid after the adsorption tests appeared well separated and essentially in the powdery phase. On the contrary, the nanotubes treated with diesel appeared in a highly agglomerated phase. No substantial difference in the appearance of the nanotubes after the tests was evident between the functionalized and nonfunctionalized nanotubes for the same pollutant treated.
Figure 16a,b and
Figure 17a,b show the EDS spectra of the carbon nanotubes after the adsorption tests with nonfunctionalized and functionalized nanotubes, respectively, with benzoic acid and diesel.
Table 3 reports the carbon/oxygen ratios of the carbon nanotube samples before and after the adsorption tests according to the EDS data.
The data reported in the
Table 3 suggest the following:
- (I)
Regardless of the pollutant treated, benzoic acid or diesel, the functionalized nanotubes always presented a lower C/O ratio than the nonfunctionalized ones, confirming the good effect of the functionalization, which resulted in an increase in oxygen and which was also found after the adsorption tests.
- (II)
In all types of the test, with benzoic acid or diesel, the nonfunctionalized nanotubes always showed a lower C/O ratio compared to those not used in the adsorption tests. This suggests the onset of an oxidation phenomenon, which becomes even more important in the tests with diesel.
- (III)
The functionalized nanotubes presented a lower C/O ratio in the case of the tests with diesel, once again suggesting the same hypothesis as the previous point.
- (IV)
However, in the case of the functionalized nanotubes used in the tests with benzoic acid, there was, on the contrary, an increase in the C/O ratio compared to those not used in the tests. In fact, the values of the C/O ratio increased from 5.16 to 11.47. This value, which seems to contradict the general trend, can be explained by the fact that although an oxidation phenomenon may have occurred, it become less noticeable since the prevailing fact is that the functionalized carbon nanotubes allow for more molecules of benzoic acid to be adsorbed thanks to a greater affinity. For each molecule of adsorbed benzoic acid, there are six carbon atoms (72) and two oxygen atoms (32), which lead to an increase in the C/O ratio.
During the adsorption tests, the carbon nanotubes were subjected to stress both due to the agitation to which the system is subjected and the recovery and filtration phases. Under these conditions, it is possible for some bonds to break near defects, leading to the formation of active sites for oxidation reactions. In the case of diesel, because of the greater viscosity of the system, the stressful action that occurs during the adsorption tests is more important, with a consequent increase in the oxidation phenomenon.
Below are SEM images of the nonfunctionalized and functionalized carbon nanotubes after the absorption tests with benzoic acid (
Figure 18) and with diesel (
Figure 19).
The appearance of the nanotube forms used in the diesel adsorption tests suggests that the adsorption occurred mainly at the surface level, where the large diesel molecules act as a glue, creating a mixture between the adsorbed diesel and nanotubes (
Figure 19). In the case of the nanotubes used in the adsorption with benzoic acid, the different nature of the molecules compared to those of diesel did not create this strong congestion between adsorbed pollutant molecules and carbon nanotubes (
Figure 18).
This different aspect suggests that carbon nanotube recovery treatments will have to include different phases regarding their regeneration.
4. Conclusions
In this article, two states of water pollution were taken into consideration, comparing the nature and chemical characteristics of the pollutants with the characteristics of carbon nanotubes and, particularly, their functionalization.
In the two case studies, benzoic acid and diesel were taken into consideration as water pollutants, as they have different chemical characteristics. Benzoic acid is soluble in water and is a polar molecule; diesel in water forms a two-phase system and contains nonpolar molecules.
The data obtained show that the nature of the carbon nanotubes is determined for effective adsorption and must be carefully chosen depending on the pollutant to be treated.
In particular, nonfunctionalized nanotubes are hydrophobic, and this means that if the pollutant is dispersed in water, as in the case of benzoic acid, they are unable to disperse adequately in the system with the consequent formation of agglomerates and reduction in access routes for the pollutant toward the active surface of the carbon nanotubes. Using functionalized carbon nanotubes instead, there is an increase in the hydrophilic character with a consequent increase in dispersion and affinity with the polar molecule and with a consequent increase in the purifying action.
In the case of water contaminated by diesel, no variation in the purifying action between the functionalized and nonfunctionalized nanotubes was evident. This can certainly be attributed to the two-phase nature of the water/diesel system. In the case of the nonfunctionalized carbon nanotubes, which have a greater hydrophobic character, when they are inserted into the system they immediately disperse in the organic phase of diesel, with consequent adsorbent action.
When functionalized nanotubes are used, thanks to their hydrophilic character, they can disperse adequately in the aqueous phase, where they can perform in a similar manner to nonfunctionalized ones in terms of the adsorbent action.
In summary, it is possible to conclude that functionalization played a significant role in the purification of water contaminated by benzoic acid, while no substantial variation was exhibited between functionalized and nonfunctionalized nanotubes in water contaminated by diesel.
Generalizing the data obtained, it is possible to say that, if the pollutant is soluble in water, the functionalization of the carbon nanotubes results in a substantial improvement in the purifying action.
If the system is biphasic, there is no substantial difference between the functionalized and nonfunctionalized nanotubes if a sufficient interfacial surface from which the functionalized nanotubes can act is guaranteed.